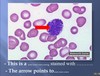
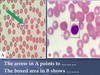

rough endoplasmic reticulum

golgi apparatus





simple squamous

-Green arrow: 2 cell membranes
-Red arrow: Intercellular space
-Star: Cytoplasm

A. Structure outlined by red rectangle is → Cell
membrane of 2 adjacent cells
B. Give 1 visible character of A → 2 dark & 1
pale layers or trilamellar or ……
C. Mention the structure marked by blue star →
Cytoplasm.
D. Green arrow point to → Intercellular space.

• Mitochondria
• Blue arrows: cristae
• Red arrowhead: Matrix

A. Organelle pointed to by blue star is called →
mitochondrion.
B. - Red arrows point to → cristae
- Green arrow points to → matrix.
C. Organelle pointed to by yellow arrows is →
rER.
D. Any 1 visible character for C → parallel
tubules or covered by ribosomes

- rER
- Arrows: ribosomes, Function: protein synthesis

- Red arrow: rER
- Green arrow: Mitochondria
- Stain: Iron hematoxylin or Janus green
- Visible feature: Cristae, ……….

- sER
- Visible features: Smooth surface, no
ribosomes, vesicles of different size and
shape …..

A. Red arrow demonstrates → Golgi
apparatus in nerve cell.
B.One visible feature of organelle is → fine
fibrils or granules & its position is →
perinuclear.
C. It is stained → brown with → silver stain.
D. Green arrow points to → nucleus & 1
visible feature is → central or rounded

A. Red arrows demonstrate → Golgi
apparatus in → secretory cells.
B. Any one visible feature of organelle is →
fine fibrils or granules & its position is →
apical.
C. It is stained → brown with → silver stain.
D. Green arrows point to → cell membrane.

A. Organelle is called → Golgi apparatus & its
nickname is → secretory apparatus.
B.- Yellow star marks → Golgi saccules.
- Any 1 visible character for B → parallel OR
one above
the other OR form stack or ……..
C. Structure by blue star → Cytoplasm
D. - Red arrow points to → transfer vesicles
- green arrow points to → secretory vesicles.

- Golgi apparatus
- Green arrow: Secretory vesicle
- Yellow arrow: Transfer vesicle

- Centriole
- Red arrow: Microtubules
- Arranged as 9 triplets

- Axoneme (Shaft) of cilium
- Yellow arrows: microtubules as 9 doublets
- Blue arrows: two singlets of microtubules

A.- Red square surrounds → shaft of cilium OR
axoneme,
- Any 1 character → formed of microtubules OR
formed of 20 microtubules or large.
B. - Blue arrow points to → 2 microtubules
- red arrow points to → peripheral microtubules.
C. - Blue square surrounds → microvilli,
- any 1 character → no microtubules
D. Yellow arrows points to → cell membrane.

A. Inclusions in fig. a → Glycogen & b lipid OR fat.
B. The used stains for fig. a →
PAS & b → Sudan III.
C. Any 1 visible character for fig. a → red granules
→ large droplet OR orange in color
D. The cell in fig. a → liver cells & b → fat cells OR
adipocytes
-Blue arrow: nucleolus

-Blue arrow: nucleolus
-Red arrow: nuclear membrane

A. The structure (be specific) → heterochromatic
nucleus.
B. - Red arrow → peripheral heterochromatin &
green arrow → chromatin island.
C. Yellow arrow → nucleolus associated
chromatin & yellow star → nuclear sap OR
euchromatin.
D. Arrowhead points to → nuclear membrane.

A. The structure (be specific) → euchromatic
nucleus.
B. Red arrow → peripheral heterochromatin &
green arrow → chromatin island.
C.Yellow arrow points to → nucleolus & yellow
star marks → nuclear sap or euchromatin.
D. Black arrow → nuclear membrane &
arrowhead → nuclear pore.